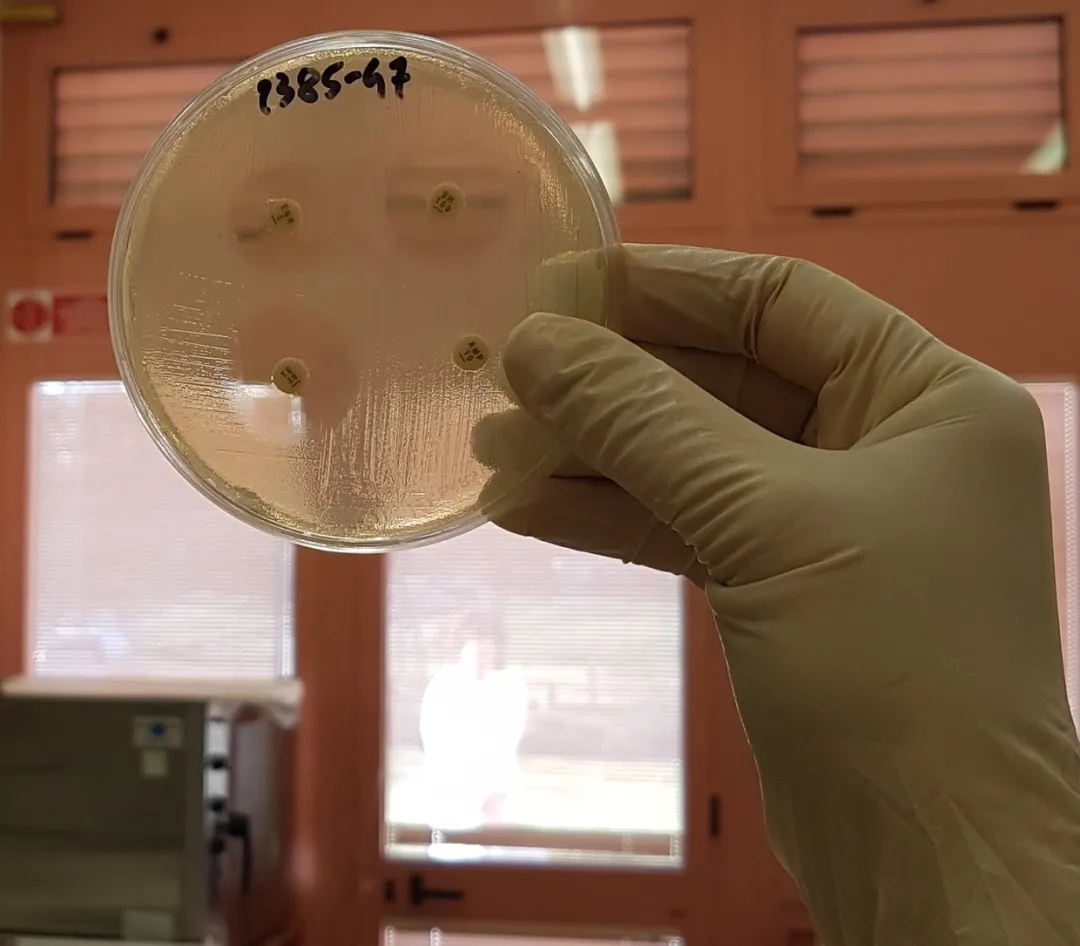

上联合学位的专业是什么体验?很爽。
选择联合学位课程,在研究生在读期间,可一年换一个城市,对想感受不同城市风情的同学来说,是个不错的选择。
甚至可以打通2个学校的资源,学他们最具核心竞争力的课程部分。
以一个专业为例来介绍一下:

联合学位是什么?
就是几个大学一起合办的专业,像是博洛尼亚大学就有相应的联合学位课程。
举个栗子,食品安全和食品风险管理硕士学位(MSc)就是由博洛尼亚大学,圣心天主教大学的piacenza校区,摩德纳大学的Emilia校区,费拉拉大学,帕尔马大学联合办的。

第一年需要去帕尔马大学就读,第二年则需要选择专业方向去对应的大学。
大学的福利不会少,甚至只会更多。
l 可以参加Erasmus +计划,可以去其他国家交换3-12个月,并且免除你的部分费用。
l 去交流国家涵盖600+大学,可有针对性选择你想去的大学,部分有补助金。
l 为联合学位课程的学生提供流动性补助,名单会在竞赛或者网站上发布。
l 更多的工作经验,不管是去海外还是去意大利本国相关的组织。
如果参加联合学位的课程,学习会更有宽度,深刻体现了“读万卷书,行万里路”。
但要提醒同学们,去读研究生主要还是看本科课程的匹配度,再看看是否有相关的联合学位课程。

课程设置
我们来看看食品安全和食品风险管理硕士学位(MSc)
LM-70 - Food science
授课语言:英语

在博洛尼亚大学如果满足分数要求,则有机会免除第二周期学位课程第一年入学的学生的学费。好好学习,孩子们。


第一年在帕尔马打基础,第二年就可以看你选的专业方向了。
也因为第一年在帕尔马,所以必须注册帕尔马大学。换帕尔马大学的官网给你们扒拉入学

入学要求
按着今年的要求来瞅瞅

需要在7月16日之前在帕尔马大学的系统中注册

在7月1日-31日之前提交入学申请。
明年估摸着也是这个时间了,仅供参考
注册流程:
首先,必须在大学信息系统(ESSE3)中注册获得凭据
如果您在7月16日之前注册,则可以在注册开始时按注册的时间顺序直接进行 访问课程的预定,并在 整个年级提高成绩,而不必重新输入注册期间所要求的数据注册
所需材料:
个人相关数据
护照
税号
高中毕业证/学位证书
护照尺寸的数码照片
居住地址,住所和个人电子邮件地址
注册结束将获得用户名和密码激活码,以此登录大学信息系统。
另外这个专业属于自由进出专业,入学难度比较小,主要还是看跟本科课程的匹配度。
在线注册以后发邮件咨询提交的相关材料。
你想去了解什么专业呢?
咨询留学宝宝
关注「意大利留学的那些事儿」
意大利留学不迷路